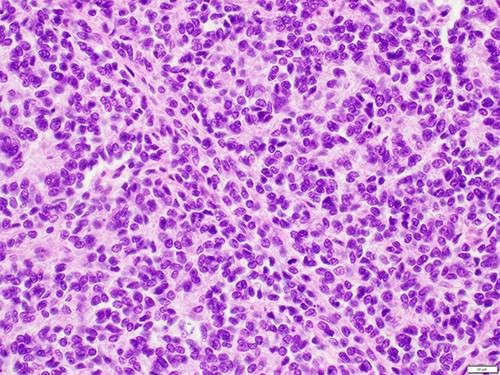
High-powered haematoxylin and eosin showing a uniform population of tumour cells with indistinct cell borders, irregular nuclei with fine dense chromatin and occasional mitotic figures.

-
PDF
- Split View
-
Views
-
Cite
Cite
Beau Knight, Gary Brierly, George Dimitroulis, Ewing sarcoma of the facial soft tissues—a case report, Journal of Surgical Case Reports, Volume 2022, Issue 2, February 2022, rjac040, https://doi.org/10.1093/jscr/rjac040
Close - Share Icon Share
Abstract
Ewing sarcoma (ES) is an uncommon malignancy of the maxillofacial region, primarily affecting the long bones and pelvis of the paediatric population. Within the head and neck, the facial skeleton is responsible for the majority of reported cases. ES poses a challenge to Oral and Maxillofacial Surgeons due to its rarity and its aggressive nature. This case report is of a 35-year-old female with primary ES in the buccal soft tissues—the first reported case of its kind.
INTRODUCTION
Ewing sarcoma (ES) is a malignant, small round blue cell neoplasm that primarily affects the long bones and pelvis, presenting in childhood and adolescence [1]. It was first described by Dr James Ewing in 1921 as a diffuse haemangioendothelioma of bone and its aetiology has since remained unknown [2]. In addition to the traditional Ewing tumour of bone, the Ewing sarcoma family of tumours (ESFT) consists of extraskeletal Ewing tumours (20–30%) and primitive neuroectodermal tumours including those of the chest wall (Askin tumours) [3, 4]. The first case of extraskeletal ES was reported by Angervall and Enzinger in 1975 and is thought to account for 20–30% of all ES cases [3].
Characteristically, all of the ESFT are derived from neural crest cells and the majority demonstrate reciprocal translocation of chromosomes 11 and 22 (q24;q12), resulting in the fusion of EWS and FLI-1 genes and subsequent production of an oncogenic transcription factor [5].
ES is the second most prevalent malignant primary bone tumour after osteosarcoma. It is predominantly found in the lower limb, with the femur, pelvis, humerus, spine and ribs commonly affected [6]. The maxillofacial region represents 2–3% of all ES diagnoses, with cases being reported in the skull and facial skeleton [7]. In total, 95% occur between the ages of 4 and 25, with a male predilection (M:F 3:2) [8].
CASE PRESENTATION
A 35-year-old Caucasian female presented to an Oral and Maxillofacial Surgeon, reporting a firm, painless lump within her left cheek, progressively enlarging over 12 months. She was otherwise well with no constitutional symptoms, no significant medical history, had never smoked and rarely consumed alcohol.
On examination, a 3 × 3cm firm mass was adjacent to the mandibular body with no cutaneous or mucosal changes. It was anterior to the parotid gland and masseter (Fig. 1). Dental examination and orthopantomogram excluded odontogenic origin. There was no palpable cervicofacial lymphadenopathy. Systemic examination was unremarkable.

The surgeon performed an intraoral excision of the lesion under general anaesthetic (Fig. 2). It was well circumscribed and confined within the buccal soft tissues. The lesion was removed intact and primary mucosal closure achieved.

Appearance of lesion following buccal sulcus incision and dissection.
The gross specimen was a 30 × 23 × 20 mm tan fibrofatty mass (Fig. 3). Microscopically, skeletal muscle fibres were infiltrated by epithelioid tumour cells with abundant, pale, eosinophilic cytoplasm and mildly pleomorphic hyperchromatic nuclei with inconspicuous nucleoli. Patchy pseudoacini and rosette formation were present, with increased apoptosis and geographic necrosis. No lymphovascular or perineural invasion was seen (Fig. 4).

A wide panel of immunostaining was performed, with tumour cells positive for CD99 (Fig. 5), CD56 and CD117, and weak non-specific staining for BCL2 and CD57. These features were suggestive of a round cell neoplasm with neuroendocrine differentiation. Confirmatory EWSR1/FL1 FISH studies established the diagnosis of ES.
High-powered haematoxylin and eosin showing a uniform population of tumour cells with indistinct cell borders, irregular nuclei with fine dense chromatin and occasional mitotic figures.

High-powered CD99 demonstrating strong diffuse membranous staining.
The patient was referred to a tertiary public hospital for multidisciplinary discussion and treatment. Cross-sectional and nuclear imaging demonstrated no focal uptake at the site of excision and no evidence of regional or distant metastases. Adjuvant chemotherapy with VDC/IE (vincristine-doxorubicin-cyclophosphamide/ifosfamide-etoposide) was ceased after the third cycle due to severe fatigue. The patient has been offered a further wide local excision to ensure negative margins and is for consideration of post-operative radiation therapy.
DISCUSSION
Oral and Maxillofacial Surgeons frequently diagnose and treat soft tissue lesions of the head and neck. They can be further categorised as to whether they are odontogenic, traumatic, infective or neoplastic [9]. Within the buccal tissues, typical differential diagnoses for a painless, enlarging, non-odontogenic mass includes lipoma, sebaceous and epidermoid cyst, lipoma, mucocoele and salivary gland tumour. Malignant tumours account for ~5% of all oral and maxillofacial pathology [10].
The maxillofacial region is responsible for 2–3% of ES cases—the vast majority involving the maxilla, mandible and zygoma. They most commonly present as a firm swelling, both with and without pain [11]. In the present case, the surgeon suspected a benign lesion of non-odontogenic origin such as a lipoma due to its consistency and discrete nature. The decision was made to excise to improve patient comfort as well as exclude malignancy.
ESFT represent a single tumour entity with common antigenic profiles, cytogenetic aberrations and protooncogene expression. Previous authors have attempted to elucidate the origin of this group of tumours, with evidence suggesting human marrow mesenchymal stem cells to be responsible. Over 90% demonstrate specific translocations t(11;12)(q24;q12) and consequent EWS–FLI1 genetic fusion, initiating ES cancer stem cells [4].
Treatment of ES usually includes excision, along with radiotherapy and/or chemotherapy. The most favourable prognostic factor is lack of distant metastasis at diagnosis, with a 5-year survival rate of 42% in a localised lesion versus 15% in metastatic disease [12]. In terms of primary tumour location, superficial soft tissues are most favourable, followed by distal extremities, ribs and pelvis. It has been suggested that ES affecting the maxillofacial region may have a better prognosis, attributable to patients seeking earlier medical attention for more readily noticeable symptoms affecting facial appearance, speech and mastication [13].
This 35-year-old patient was managed in a tertiary high volume multidisciplinary setting. She unfortunately suffered intolerable side effects due to the chemotherapy and was unable to complete the seven total cycles. The patient has been offered a further wide local excision to ensure negative margins and is for consideration of post-operative radiation therapy.
CONCLUSION
A unique case of a buccal soft tissue ES in an adult female is presented, which has not been previously reported in the literature. Many different lesions affect the soft tissues of the maxillofacial region, but the rarity and lack of published literature regarding ES in the facial soft tissues represents a diagnostic and therapeutic challenge. This report demonstrates that although rarely encountered, ES and other round cell tumours of the face should be considered. A multidisciplinary treatment approach and close surveillance for recurrence is essential for its successful management.
CONFLICT OF INTEREST STATEMENT
None declared.